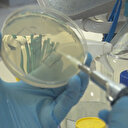

Wuhan'da ikinci koronavirüs dalgası resmen başladı.
Koronavirüsten (Covid-19) salgınının başladığı ve enfekte olan kişilerin neredeyse sıfıra indiği Çin’de vaka sayısı yeniden yükselişe geçti. Ülkede haftalar sonra 51 kişide virüs tespit edildiği açıklandı.
Koronavirüsten (Covid-19) salgınının başladığı ve enfekte olan kişilerin neredeyse sıfıra indiği Çin başladığı noktaya yeniden döndü.Ülkede vaka sayısı haftalar sonra yeniden yükselişe geçti.
- Koronavirüsten enfekte olan kişilerin neredeyse sıfıra indiği Çin’de vaka sayısı artmaya devam ederken ülke 51 kişide virüs tespit edildiğini ve çoğunun virüsün ortaya çıktığı Vuhan’da olduğunu açıkladı.
İçlerinde hiçbir belirti göstermeyen asemptomatik 40 vakanın olduğu bildirildi.
Yetkililer, salgının başladığı kent olan Vuhan’da son 10 günde 6 milyonun üzerinde testin yapıldığını belirtti.
#Wuhan
#Çin
#Koronavirüs